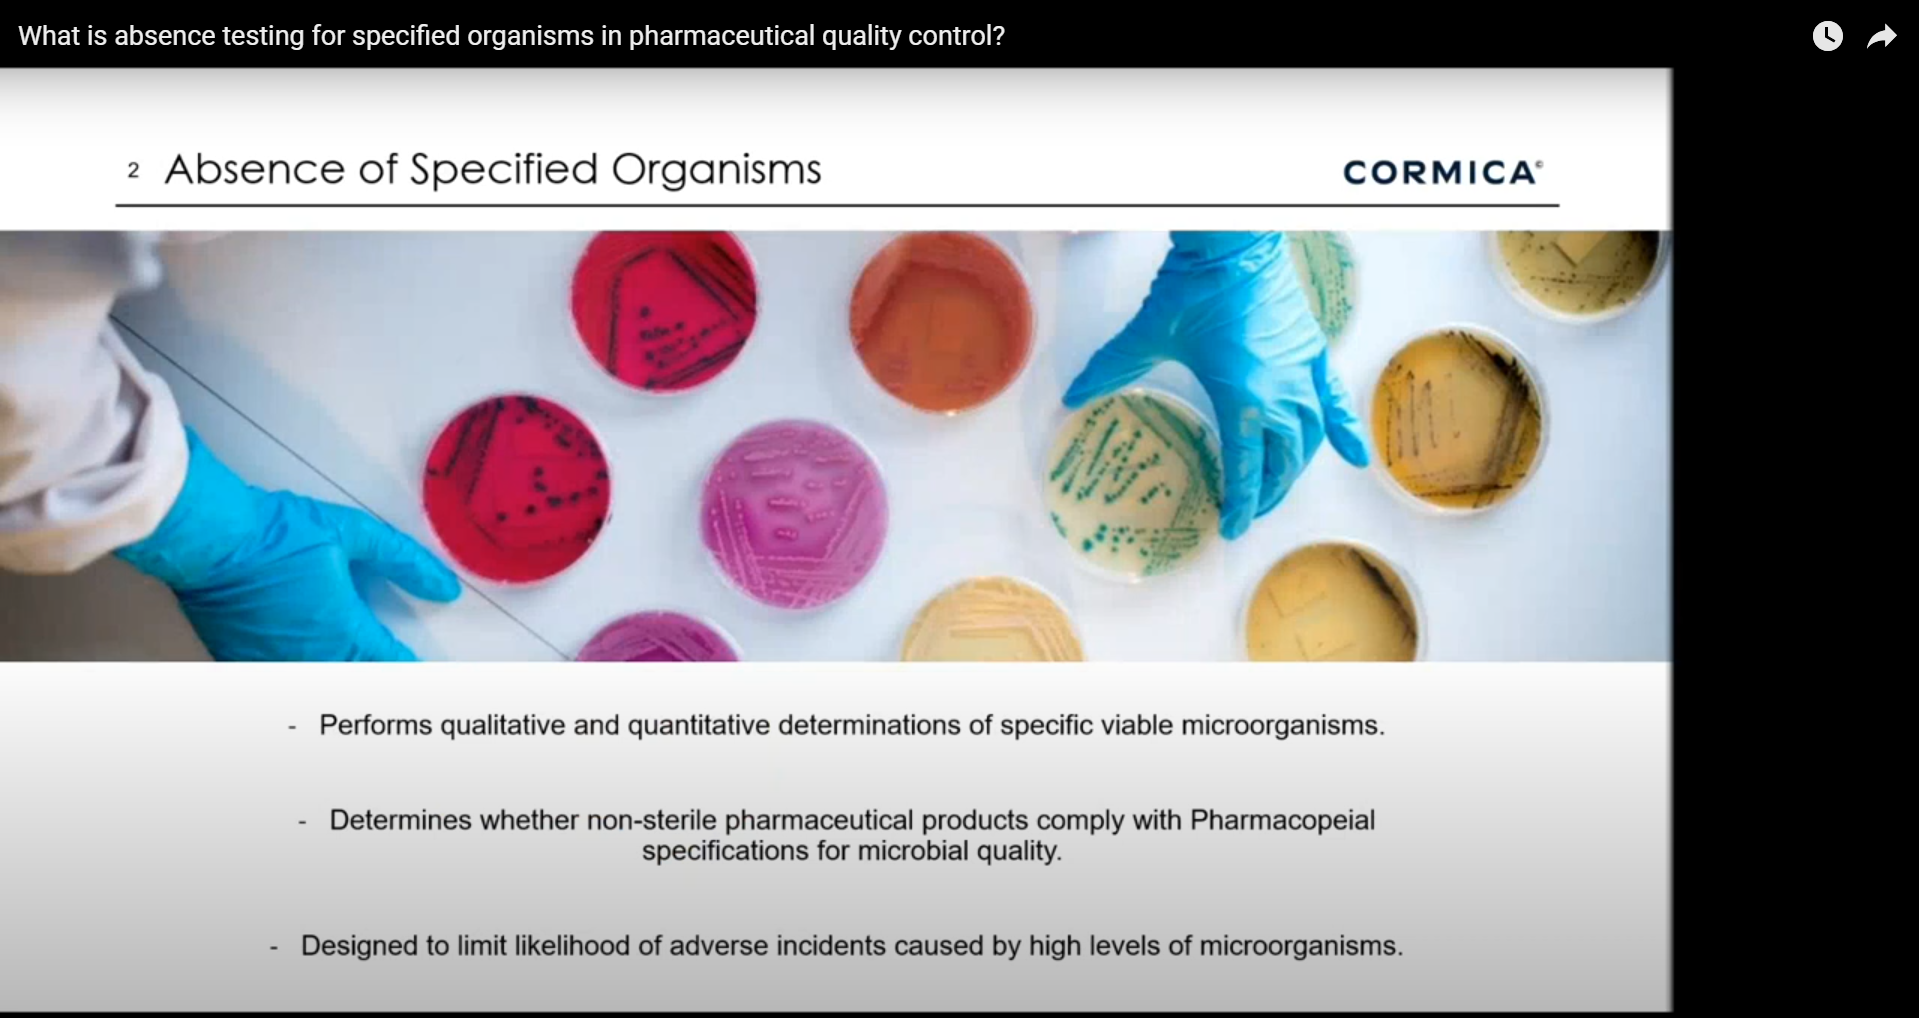
What is absence testing for specified organisms in pharmaceutical quality control?

Why Is the Absence of Specified Organisms Crucial in Pharmaceutical Quality Control?

Download our webinar and explore the critical importance of microbial testing in quality control. Join as our expert microbiologists share their extensive knowledge and experience, offering a comprehensive understanding of regulatory standards, best practices, and advanced techniques.
During this informative session, you will learn how to identify potential routes of entry for contaminants and determine the necessary microorganism tests to maintain the integrity and safety of your products. Understanding these key aspects is vital for preventing contamination and ensuring that your products meet the highest safety standards. Our experts will guide you through the latest industry regulations, helping you stay compliant and avoid costly compliance issues.
Don’t miss this opportunity to gain invaluable knowledge and network with industry peers and experts. Whether you are looking to update your current processes or seeking to deepen your understanding of microbial testing, this webinar is designed to provide you with the tools and insights needed to ensure your products remain safe and compliant. Download the webinar and take a significant step towards enhancing your quality control processes.
You’ll learn:
- The critical importance of microbial testing in quality control for pharmaceuticals and medical devices.
- How to identify potential routes of entry for contaminants.
- Determining necessary microorganism tests to maintain product integrity and safety.
- Understanding and staying compliant with the latest industry regulations.
- Best practices for microbial testing that can be immediately applied to your processes.
- Advanced techniques in microbial testing to improve efficiency and effectiveness.
- Strategies to enhance your quality control protocols and prevent contamination.

Cormica’s mission is to improve patients’ lives by providing comprehensive testing services, enabling clients to launch and release their products safely and rapidly across the world.
Don’t miss out on this opportunity to enhance your knowledge and improve your understanding of critical industry processes and standards. Download the webinar today.
Webinar Clips

0:57

0:55

1:12
1:14

1:00

1:47

0:51

1:19

0:42
Download Our Webinar!
Type:
Authors:
Presenters: Daisy Hirst (Lead Scientist) and Alisha Bartholomew (Scientist) both at Wickham Micro, a Cormica lab.

Daisy Hirst is a Senior Scientist in the Quality Control (QC) department at Wickham Micro Limited after joining a year ago. She graduated from university with First-Class Honors in Biomedical Sciences with a certificate of excellence in pharmacology and toxicology. During university she focussed research on epithelial cell responses when confronted with bacterial infection. Daisy specialises in microbiology, particularly in microbial plate reading, approval of results and root cause analysis into out of specification results.

Alisha Bartholomew is a Scientist in the Quality Control (QC) department at Wickham Micro Limited. She graduated with a degree in Biochemistry and pursued a Master’s degree focusing on a novel pharmacological treatment for a rare genetic disorder. Alisha has been with Wickham Micro for nearly 18 months, during which she has expanded her expertise into plate reading and the identification of microorganisms.